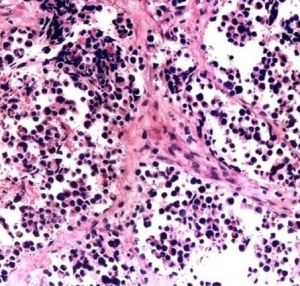
腺泡狀排列

軟組織腫瘤概述
軟組織惡性腫瘤,又稱組織肉瘤,僅占全部惡性腫瘤的1%左右。在兒童期軟組織肉瘤的發病次於白血病、腦腫瘤和淋巴瘤,居第四位。在軟組織肉瘤中最常見的是纖維肉瘤、滑膜肉瘤、橫紋肌肉瘤、脂肪肉瘤、平滑肌肉瘤和間皮肉瘤等。軟組織腫瘤流行病學
大部分軟組織腫瘤的病因還不清楚。只發現有少數腫瘤(大部分是惡性軟組織肉瘤)的發生與遺傳、環境因素、放射線、病毒感染和免疫缺陷有關。也有個別病例報導軟組織肉瘤發生於瘢痕組織、骨折部位和外科手術植入部位。絕大部分軟組織肉瘤的發生沒有明顯的原因。一些惡性間葉腫瘤發生於家族性腫瘤綜合徵。在軟組織腫瘤中沒有發現明顯的多步癌變現象,如:隨著遺傳突變積累而組織學上惡性程度逐漸增加的情況。化學致癌劑
有幾個研究報告(許多來自瑞典)報導接觸苯氧乙酸除草劑、氯酚和農業、林場二氧雜芑污染物後軟組織肉瘤發病率提高。而有些研究則沒有發現。得出不同研究結果可能是由於各自使用不同的除草劑而造成的。放射線
曾有報導放射線照射後的肉瘤發生率在千分之幾到近百分之一。這些發生率大部分是通過接受放療的乳腺癌病人得出的。隨著放射劑量的增加,患病幾率也增加。大部分病人接受50Gy的放射劑量,儘管有些證據表明潛伏期在逐漸縮短,但從接受照射到診斷腫瘤的平均時間是大約10年。這些腫瘤中一半以上分類為所謂的惡性纖維組織細胞瘤,大部分為高惡性。具有視網膜母細胞瘤基因(RB1)胚系突變的患者發生放射後肉瘤的幾率明顯提高,通常發生肉瘤。病毒感染和免疫缺陷
人皰疹病毒8在Kaposi肉瘤的發生中有很關鍵的作用,而且腫瘤的臨床經過與病人的免疫狀態密切相關。EB病毒與免疫缺陷病人的平滑肌腫瘤相關(1368)。Stewart-Treves綜合徵是指發生於慢性淋巴水腫的血管肉瘤,尤其是發生於乳腺癌根治術後的病例,有些作者將其歸因於局部的獲得性免疫缺陷。遺傳易感性
 軟組織腫瘤
軟組織腫瘤惡性軟組織腫瘤通常生長迅速、體積巨大,浸潤和破壞周圍正常組織。腫瘤本身可有壞死、出血及繼發感染,並且經常有廣泛的血行播散轉移至肺、骨、皮下、腦、腎上腺、胰腺等臟器。患者往往死於惡液質,嚴重出血及廣泛轉移;各種類型的惡性軟組織腫瘤的惡性程度也有顯著差別,根據其血行轉移多少可粗略地分為三類:高度惡性的有圓型細胞脂肪肉瘤、多形性脂肪肉瘤、腺泡狀橫紋肌肉瘤、滑膜肉瘤、血管內皮肉瘤、淋巴管肉瘤等;中度惡性的有深部惡性巨細胞瘤、多形性橫紋肌肉瘤、透明細胞肉瘤、平滑肌肉瘤等;低度惡性的有上皮樣肉瘤、淺部惡性巨細胞瘤、纖維肉瘤、高分化的黏膜脂肪肉瘤等。
軟組織肉瘤共同的特點為:體積比其相應的良性腫瘤大,一般都無包膜。但肉瘤因生長迅速而將周圍正常組織壓縮,可形成假包膜,鏡下觀察與周圍正常組織無明顯界限。
軟組織肉瘤
1.腺泡狀排列:
腺泡狀排列
腺泡狀排列可見於腺泡狀軟組織肉瘤和腺泡狀橫紋肌肉瘤;
2.腺腔樣排列:
可見於滑膜肉瘤、間皮瘤、神經鞘瘤、惡性外周神經鞘膜瘤;
3.雙相分化排列:
可見於滑膜肉瘤和間皮瘤;
4.索狀排列:
可見於上皮樣血管內皮瘤、骨外粘液樣軟骨肉瘤、上皮樣惡性外周神經鞘膜瘤、圓細胞脂肪肉瘤(罕見)。
5.束狀排列:
可見於瘤樣纖維組織增生(韌帶樣瘤)、纖維肉瘤、惡性外周神經鞘膜瘤、滑膜肉瘤;
6.內分泌樣排列(細胞巣):
可見於副節瘤、腺泡狀軟組織肉瘤;
7.小葉狀結節性巢樣排列:
可見於脂肪母細胞瘤、脂肪肉瘤、上皮樣肉瘤、透明細胞肉瘤、嬰兒纖維性錯構瘤、神經鞘粘液瘤;
8.柵欄狀排列:
可見於神經鞘瘤、惡性外周神經鞘膜瘤、平滑肌肉瘤、惡性蠑螈瘤(罕見)、滑膜肉瘤(罕見);
9.叢狀排列:可見於神經纖維瘤、神經鞘瘤、叢狀纖維組織細胞瘤;叢狀毛細血管排列者可見於粘液型脂肪肉瘤、粘液型惡性纖維組織細胞瘤;
10.血管外皮瘤樣排列:
可見於血管外皮瘤、滑膜肉瘤、間葉性軟骨肉瘤、平滑肌肉瘤、惡性外周神經鞘膜瘤、瘤樣肌纖維母細胞增生、腎小球旁細胞瘤、胸膜和腹膜孤立性纖維瘤、脂肪肉瘤(罕見);
11.菊型團或假菊型團樣排列:
可見於神經母細胞瘤、原始神經外胚葉瘤、神經母細胞瘤樣神經鞘瘤、惡性外周神經鞘膜瘤(罕見)
12.車輻狀排列:
見於隆突性皮膚纖維肉瘤、纖維組織細胞瘤、惡性纖維組織細胞瘤、去分化脂肪肉瘤、惡性外周神經鞘膜瘤、神經纖維瘤、神經束膜瘤=顱外腦膜瘤;
13.管狀-乳頭狀排列:
可見於間皮瘤、椎管外室管膜瘤。
軟組織腫瘤診斷
根據病史和臨床表現,軟組織腫瘤是不難與非腫瘤性腫塊鑑別的,其診斷要點如下:
(一)患者在幾周或幾個月的時間後才覺察到無痛性進行性增大的腫塊,發熱、體重下降及一般的不適等全身性症狀則少見。
 軟組織腫瘤影像
軟組織腫瘤影像(三)X線攝片檢查X線攝片有助於進一步了解軟組織腫瘤的範圍,透明度以及其與鄰近骨質的關係。如邊界清晰,常提示為良性腫瘤;如邊界清楚並見有鈣化,則提示為高度惡性肉瘤,該情況多發生於滑膜肉瘤、橫紋肌肉瘤等。
(四)超聲顯像檢查該法可檢查腫瘤的體積範圍、包膜邊界和瘤體內部腫瘤組織的回聲,從而區別良性還是惡性。惡性者體大而邊界不清,回聲模糊,如橫紋肌肉瘤、滑膜肌肉瘤、惡性纖維組織細胞瘤等。超聲檢查還能引導作深部腫瘤的針刺吸取細胞學檢查。該檢查方法確是一種經濟、方便而又無損於人體的好方法。
(五)CT檢查由於CT具有對軟組織腫瘤的密度分辨力和空間分辨力的特點,用來診斷軟組織腫瘤也是近年常用的一種方法。
(六)MRI檢查用它診斷軟組織腫瘤可以彌補X線CT的不足,它從縱切面把各種組織的層次同腫瘤的全部範圍顯示出來,對於腹膜後軟組織腫瘤、盆腔向臀部或大腿根部伸展的腫瘤、膕窩部的腫瘤以及腫瘤對骨質或骨髓侵襲程度的圖像更為清晰,是制訂治療計畫的很好依據。
(七)病理學檢查
1.細胞學檢查:是一種簡單、快速、準確的病理學檢查方法。最適用於以下幾種情況:①已破潰的軟組織腫瘤,用塗片或刮片的採集方法取得細胞,鏡檢確診;②軟組織肉瘤引起的胸腹水,必須用剛取到的新鮮標本,立即離心沉澱濃集,然後塗片;③穿刺塗片檢查適用於瘤體較大、較深而又擬作放療或化療的腫瘤,也適用於轉移病灶及復發病灶。
2.鉗取活檢:軟組織腫瘤已破潰,細胞學塗片又不能確診時,可做鉗取活檢。
3.切取活檢:多在手術中採取此法。如較大的肢體腫瘤,需截肢時,在截肢前做切取活檢,以便得到確切的病理診斷。腫瘤位於胸、腹或腹膜後時,不能徹底切除,可做切取活檢,確診後採用放療或化療。
4.切除活檢:適用體積較小的軟組織腫瘤,可連同腫瘤周圍部分正常組織整塊切除送病理檢查。
軟組織腫瘤治療措施。
治療
手術治療
 手術治療
手術治療2.減積手術:是針對一些無法完全切除的軟組織腫瘤而採用的方法,術後再繼以其他非手術治療,以期改善病人的生活質量並延長病人的生命。如惡性腹膜後巨大的脂肪肉瘤等,可先行減積手術,爾後再輔加放射治療,可取得好的療效。
3.截肢術:適用於晚期的巨大腫瘤伴有潰瘍大出血,而又無法止血;或伴發嚴重感染,如膿毒血症、破傷風等危害病人生命安全;或腫瘤生長迅速並引起劇烈疼痛,難以用藥物控制;或肢體己有病理性骨折,失去活動能力等嚴重狀況下,無法用其他方法挽救時,方可考慮先選用截肢術。
放射治療
 放射治療
放射治療化學治療
對軟組織肉瘤有效的藥物很多;主要為ADM、DTIC、CTX及IFO、KSM等。一般認為療效較好的是CYVADIC聯合方案。其具體用法是:CTX600mg、d1VCR2mgd1,KSM400μg,d1,DTIC250mgd1-5;3~4周為一療程。化學治療又分術後輔助化療及新輔助化療,即術前化療。1.手術前化療:體積較大惡性程度高的軟組織惡性腫瘤宜於術前用化療,可使瘤體縮小,提高切除率,避免截肢之苦。
2.手術後化療:手術加用化學藥物治療,已被廣泛套用於臨床各種惡性腫瘤的治療中。在治療高度惡性軟組織肉瘤中,應在手術後短期內即開始套用,有可能減少遠處轉移,提高生存率。如時間相隔太久,將難奏效。作者認為:用化療比不用好,早用比晚用好,預防性比治療性好。一般用藥時間Ⅰ期和Ⅱa期化療1年,Ⅱb~Ⅲ期化療2年。
預後
軟組織肉瘤患者的預後優於許多上皮類腫瘤,全部5年生存率在50%,預後主要取決於腫瘤組織病理學的分化程度及受累範圍,位於四肢的腫瘤預後要優於其他部位者。發生了轉移但治療仍有收效的患者,中數生存期為確診轉移後大約1年。
轉移擴散
 軟組織腫瘤
軟組織腫瘤預防警惕
外科專家介紹了軟骨肉瘤發病早期的一些症狀,提示廣大青少年,如有以下症狀要及時到醫院進行檢查:1、早期患者的患病區域會感覺不適,幾天或幾周后出現腫脹及腫塊,晚期可出現靜脈曲張,局部皮膚溫度升高及充血發紅。2、一般患者會感覺關節周圍疼痛,最初是間歇性疼痛,一段時間後逐漸加重,轉為持續性疼痛,夜間更為明顯,服用止痛藥無效。3、患者的關節活動受限,有些病人會發生關節積液,甚至會發生病理性骨折。飲食護理
1、軟骨肉瘤患者宜吃食物:(1)宜多吃具有抗骨髓病、骨肉瘤的食物,如海帶、紫菜、淡菜、海蛤、裙帶菜、杏仁、桃仁、李。
(2)骨痛宜吃龜板、鱉肉、穿山甲、牡蠣、蟹、蝦、核桃。
(3)脾臟腫大宜吃甲魚、泥鰍、海鰻、毛蚶、海帶、裙帶菜。
(4)貧血宜吃豬肝、香菇、芝麻、蜂乳、黃魚、花生、海參、鯇魚、鮑魚。
(5)化療期間宜吃甲魚、黃鱔。補白細胞的,化療需要足夠白細胞,不夠就不能化療。冬蟲夏草,可以減輕化療副作用。
2、軟骨肉瘤患者忌吃食物:(1)忌菸酒及辛辣刺激食物。
(2)忌霉變、醃製、油煎、肥膩食物。
(3)忌雞肉、羊肉、鵝肉、豬頭肉等發物。

